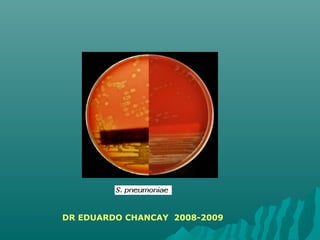
DR EDUARDO CHANCAY 2008-2009
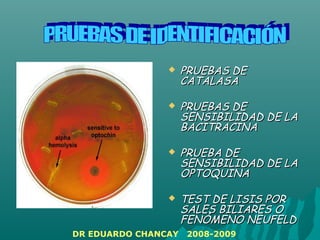
 PRUEBAS DEPRUEBAS DE
CATALASACATALASA
 PRUEBAS DEPRUEBAS DE
SENSIBILIDAD DE LASENSIBILIDAD DE LA
BACITRACINABACITRACINA
 PRUEBA DEPRUEBA DE
SENSIBILIDAD DE LASENSIBILIDAD DE LA
OPTOQUINAOPTOQUINA
 TEST DE LISIS PORTEST DE LISIS POR
SALES BILIARES OSALES BILIARES O
FENÓMENO NEUFELDFENÓMENO NEUFELD
DR EDUARDO CHANCAY 2008-2009

El documento resume las características de tres bacterias: Estreptococos, Enterococos y Neumococos. Describe que los Estreptococos son cocos Gram positivos que se agrupan en cadenas y pueden causar infecciones como faringitis y erisipela. Los Enterococos son cocos Gram positivos que crecen en pares y requieren colina. Los Neumococos son diplococos Gram positivos que causan neumonía y tienen una cápsula que se hincha con antisuero.